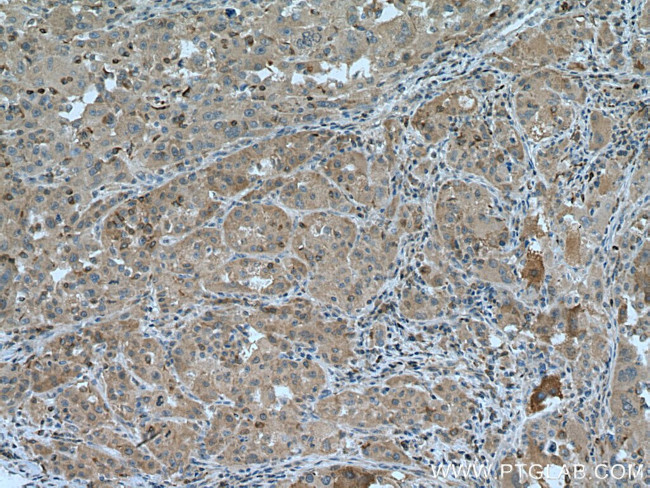
ARH Antibody in Immunohistochemistry (Paraffin) (IHC (P))

Search
Proteintech
ARH Polyclonal Antibody
{{$productOrderCtrl.translations['antibody.pdp.commerceCard.promotion.promotions']}}
{{$productOrderCtrl.translations['antibody.pdp.commerceCard.promotion.viewpromo']}}
{{$productOrderCtrl.translations['antibody.pdp.commerceCard.promotion.promocode']}}: {{promo.promoCode}} {{promo.promoTitle}} {{promo.promoDescription}}. {{$productOrderCtrl.translations['antibody.pdp.commerceCard.promotion.learnmore']}}
产品信息
13213-1-AP
种属反应
宿主/亚型
分类
类型
抗原
偶联物
形式
浓度
规格
纯化类型
保存液
内含物
保存条件
运输条件
产品详细信息
Immunogen sequence: MDALKSAGR ALIRSPSLAK QSWGGGGRHR KLPENWTDTR ETLLEGMLFS LKYLGMTLVE QPKGEELSAA AIKRIVATAK ASGKKLQKVT LKVSPRGIIL TDNLTNQLIE NVSIYRISYC TADKMHDKVF AYIAQSQHNQ SLECHAFLCT KRKMAQAVTL TVAQAFKVAF EFWQVSKEEK EKRDKASQEG GDVLGARQDC TPPLKSLVAT GNLLDLEETA KAPLSTVSAN TTNMDEVPRP QALSGSSVVW ELDDGLDEAF SRLAQSRTNP QVLDTGLTAQ DMHYAQCLSP VDWDKPDSSG TEQDDLFSF (1-308 aa encoded by BC029770 )
靶标信息
The protein encoded by this gene is a cytosolic protein which contains a phosphotyrosine binding (PTD) domain. The PTD domain has been found to interact with the cytoplasmic tail of the LDL receptor. Mutations in this gene lead to LDL receptor malfunction and cause the disorder autosomal recessive hypercholesterolaemia.
仅用于科研。不用于诊断过程。未经明确授权不得转售。
生物信息学
蛋白别名: Autosomal recessive hypercholesterolemia protein; DKFZp586D0624; LDL receptor adaptor protein; Low density lipoprotein receptor adapter protein 1; MGC34705; RP11-70P17.2; unnamed protein product
基因别名: ARH; ARH1; ARH2; FHCB1; FHCB2; FHCL4; LDLRAP1
UniProt ID: (Human) Q5SW96
Entrez Gene ID: (Human) 26119